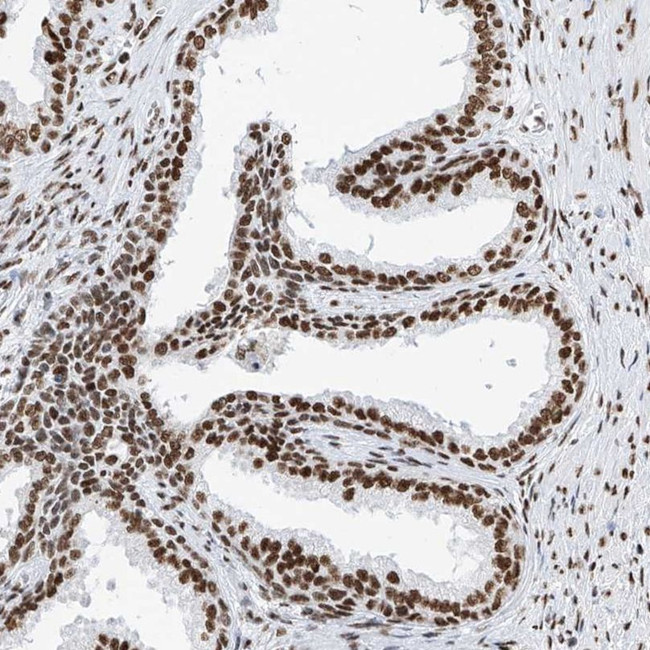
SRSF6 Antibody in Immunohistochemistry (IHC)

Search
Invitrogen
SRSF6 Polyclonal Antibody
{{$productOrderCtrl.translations['antibody.pdp.commerceCard.promotion.promotions']}}
{{$productOrderCtrl.translations['antibody.pdp.commerceCard.promotion.viewpromo']}}
{{$productOrderCtrl.translations['antibody.pdp.commerceCard.promotion.promocode']}}: {{promo.promoCode}} {{promo.promoTitle}} {{promo.promoDescription}}. {{$productOrderCtrl.translations['antibody.pdp.commerceCard.promotion.learnmore']}}
产品信息
PA5-56034
种属反应
已发表种属
宿主/亚型
分类
类型
抗原
偶联物
形式
浓度
规格
纯化类型
保存液
内含物
保存条件
运输条件
RRID
产品详细信息
Immunogen sequence: KDEYEKSRSR SRSRSPKENG KGDIKSKSRS RSQSRSNSPL PVPPSKARSV SPPPKRATSR SR
Highest antigen sequence identity to the following orthologs: Mouse - 89%, Rat - 89%.
靶标信息
SFRS6 is involved in mRNA splicing and may play a role in the determination of alternative splicing. It belongs to the splicing factor SR family and has been shown to bind with and modulate another member of the family, SFRS12. The protein encoded by this gene is involved in mRNA splicing and may play a role in the determination of alternative splicing. The encoded nuclear protein belongs to the splicing factor SR family and has been shown to bind with and modulate another member of the family, SFRS12.
仅用于科研。不用于诊断过程。未经明确授权不得转售。
生物信息学
蛋白别名: epididymis secretory protein Li 91; MGC5045; Pre-mRNA-splicing factor SRP55; Serine/arginine-rich splicing factor 6; Splicing factor, arginine/serine-rich 6; splicing factor, arginine/serine-rich, 55 kDa; SR splicing factor 6; unnamed protein product
基因别名: 1210001E11Rik; AI314910; AW146126; B52; HEL-S-91; SFRS6; SRP55; SRSF6
UniProt ID: (Human) Q13247, (Mouse) Q3TWW8
Entrez Gene ID: (Human) 6431, (Mouse) 67996